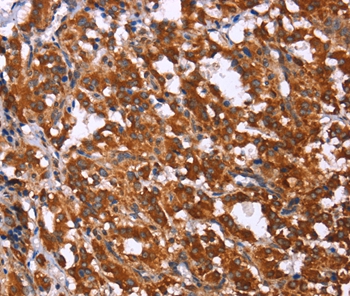
Anti-GPR65 Antibody

Immunofluorescent staining of human cell line RH-30 shows localization to cytosol.
Anti-GPR65 Antibody
HPA054454
ApplicationsImmunoCytoChemistry
Product group Antibodies
ReactivityHuman
TargetGPR65
Overview
- SupplierAtlas Antibodies
- Product NameAnti-GPR65 Antibody
- Delivery Days Customer4
- ApplicationsImmunoCytoChemistry
- CertificationResearch Use Only
- ClonalityPolyclonal
- ConjugateUnconjugated
- Gene ID8477
- Target nameGPR65
- Target descriptionG protein-coupled receptor 65
- Target synonymsTDAG8, hTDAG8, G-protein coupled receptor 65, T-cell death-associated gene 8 protein, psychosine receptor
- HostRabbit
- IsotypeIgG
- Protein IDQ8IYL9
- Protein NameG-protein coupled receptor 65
- Scientific DescriptionRecombinant Protein Epitope Signature Tag (PrEST) antigen sequence
- ReactivityHuman
- Storage Instruction-20°C,2°C to 8°C
- UNSPSC41116161